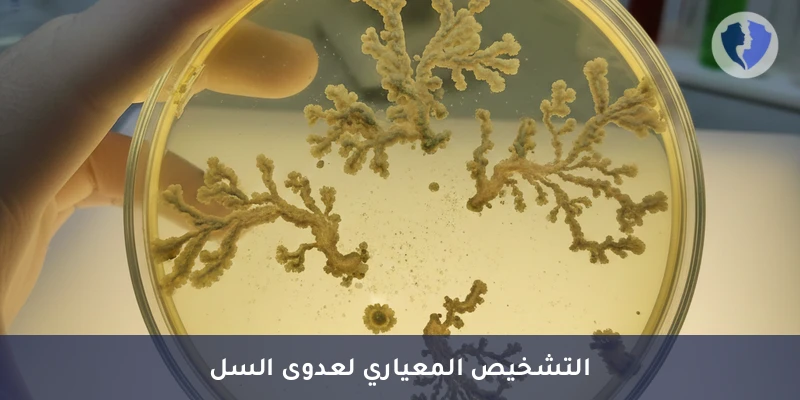
مزرعة بكتيريا الدرن الدقيقة - مزرعة بكتيريا الدرن (TB Culture)

تفاصيل الخدمة
مزرعة بكتيريا الدرن الدقيقة - مزرعة بكتيريا الدرن (TB Culture)
زراعة السل (Mycobacterium tuberculosis Culture) هي طريقة مخبرية معيارية ذهبية (Gold Standard) تستخدم لتشخيص عدوى السل النشطة. يتم فيها زرع عينة سريرية (مثل البلغم، سائل المعدة، البول، أو نسيج) على أوساط زرعية مغذية خاصة (صلبة مثل لوفنشتاين-جنسن LJ، أو سائلة مثل نظام MGIT). تهدف إلى عزل وتحديد بكتيريا المتفطرة الدرنية (MTB) وتوفير عينة حية لاختبار الحساسية للمضادات الحيوية (Drug Susceptibility Testing - DST)، وهو أمر حيوي لعلاج السل المقاوم.